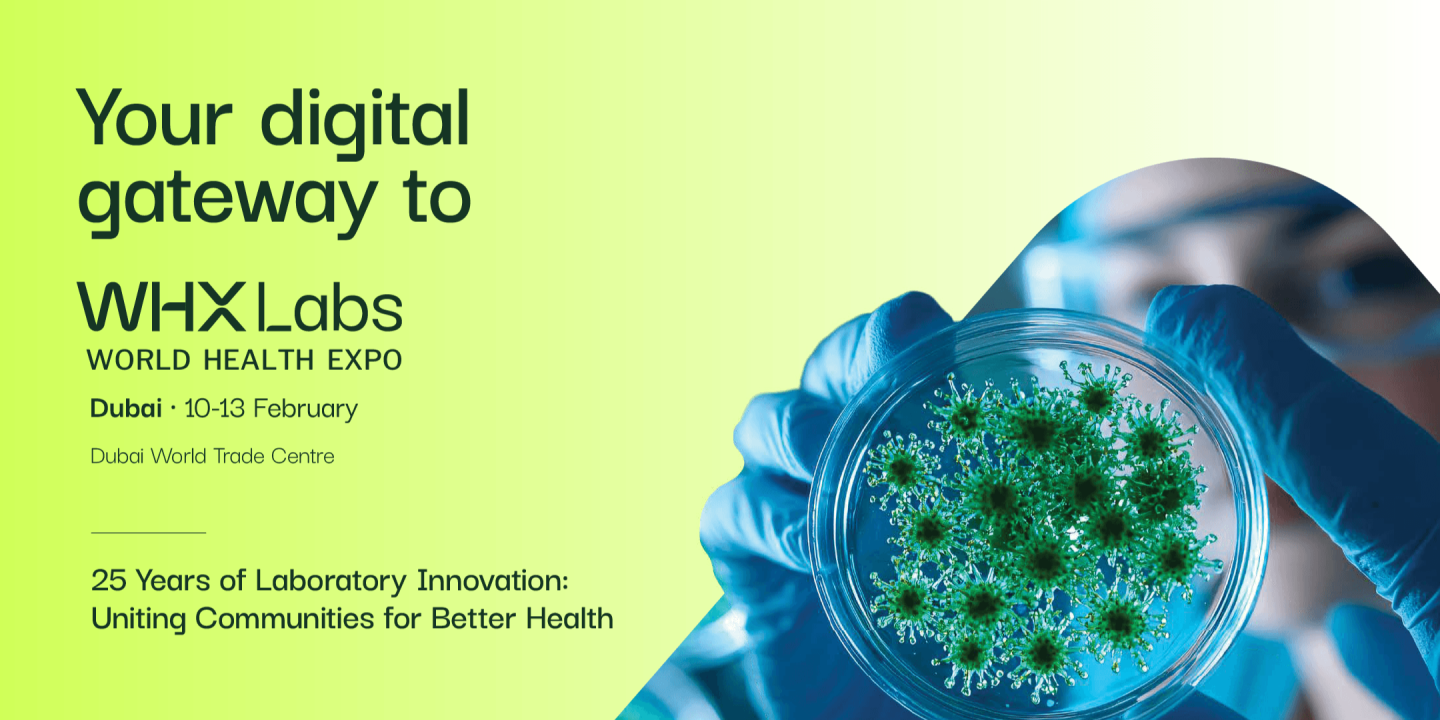
WHX Labs Dubai 2026

Explore exhibitors, products, speakers, and agenda highlights before logging in or registering.
The WHX Events App is your digital companion for WHX Labs Dubai. Once registered and logged in, you can:
The WHX Events App is designed to help you get the most out of WHX Labs Dubai, from planning your visit to making meaningful connections. With the app, you can:
Whether you’re attending sessions, exploring the exhibition floor, or following up with leads, the app ensures you save time, stay organised, and maximise your time with us.
The WHX Events App is available to everyone registered for the event. The features you can access within the app may vary depending on the ticket you have purchased or received. Guests can browse the exhibitor list, view the agenda, and explore the speaker list to get an overview of the event before registering or logging in.
We recommend using the app on different devices depending on your needs:
Yes. Full access to features such as networking, meetings, and digital badges requires a valid ticket for the event. Click here to register as an attendee and access all the app features to make the most of your participation.
Exhibitors can start using the app immediately. Attendees will gain access in January, ahead of the event, so you can plan your agenda, explore exhibitors, and start networking early.
The WHX Events App will remain open for 2–3 weeks after the live event. We recommend downloading your leads immediately after the show and continuing to network on the app during this period to follow up on conversations and generate more leads for your pipeline.
With WHX Labs Dubai moving to the new Dubai Exhibition Centre, we developed an intelligent venue navigation system to make exploring the exhibition easier than ever. The app will soon include:
In addition, the app continues to offer a range of valuable features:
Yes. WHX follows strict data protection standards to safeguard all personal and company information. For full details on how your personal information is used, see the Privacy Policy and Visitor Terms and Conditions.
Support is available in-app, including guides and contact options, to make navigating the WHX Events App smooth and effortless.
See all the content and easy-to-use features by logging in or registering!